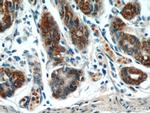
TOB1 Antibody in Immunohistochemistry (Paraffin) (IHC (P))

Search
Proteintech
TOB1 Polyclonal Antibody
{{$productOrderCtrl.translations['antibody.pdp.commerceCard.promotion.promotions']}}
{{$productOrderCtrl.translations['antibody.pdp.commerceCard.promotion.viewpromo']}}
{{$productOrderCtrl.translations['antibody.pdp.commerceCard.promotion.promocode']}}: {{promo.promoCode}} {{promo.promoTitle}} {{promo.promoDescription}}. {{$productOrderCtrl.translations['antibody.pdp.commerceCard.promotion.learnmore']}}
产品信息
14915-1-AP
种属反应
已发表种属
宿主/亚型
分类
类型
抗原
偶联物
形式
浓度
规格
纯化类型
保存液
内含物
保存条件
运输条件
产品详细信息
14915-1-AP recognizes 38 and 45 kDa bands. The additional 45 kDa band may be due to phosphorylation.
Immunogen sequence: MQLEIQVAL NFIISYLYNK LPRRRVNIFG EELERLLKKK YEGHWYPEKP YKGSGFRCIH IGEKVDPVIE QASKESGLDI DDVRGNLPQD LSVWIDPFEV SYQIGEKGPV KVLYVDDNNE NGCELDKEIK NSFNPEAQVF MPISDPASSV SSSPSPPFGH SAAVSPTFMP RSTQPLTFTT ATFAATKFGS TKMKNSGRSN KVARTSPINL GLNVNDLLKQ KAISSSMHSL YGLGLGSQQQ PQQQQQPAQP PPPPPPPQQQ QQQKTSALSP NAKEFIFPNM QGQGSSTNGM FPGDSPLNLS PLQYSNAFDV FAAYGGLNEK SFVDGLNFSL NNMQYSNQQF QPVMAN (1-345 aa encoded by B C031406)
靶标信息
This gene encodes a member of the tob/btg1 family of anti-proliferative proteins that have the potential to regulate cell growth. When exogenously expressed, this protein supresses cell growth in tissue culture. The protein undergoes phophorylation by a serine/threonine kinase, 90 kDa ribosomal S6 kinase. Interactions of this protein with the v-erb-b2 erythroblastic leukemia viral oncogene homolog 2 gene product p185 interferes with growth suppression. This protein inhibits T cell proliferation and transcription of cytokines and cyclins. The protein interacts with both mothers against decapentaplegic Drosophila homolog 2 and 4 to enhance their DNA binding activity. This interaction inhibits interleukin 2 transcription in T cells.
仅用于科研。不用于诊断过程。未经明确授权不得转售。
生物信息学
蛋白别名: MGC104792; MGC34446; proliferation-inducing gene 49; Protein Tob1; TOB1; Transducer of erbB-2 1; transducer of erbB2; transducer of ERBB2, 1; unnamed protein product
基因别名: APRO5; APRO6; PIG49; TOB; TOB1; TROB; TROB1
UniProt ID: (Human) P50616, (Mouse) Q61471
Entrez Gene ID: (Human) 10140, (Mouse) 22057, (Rat) 170842